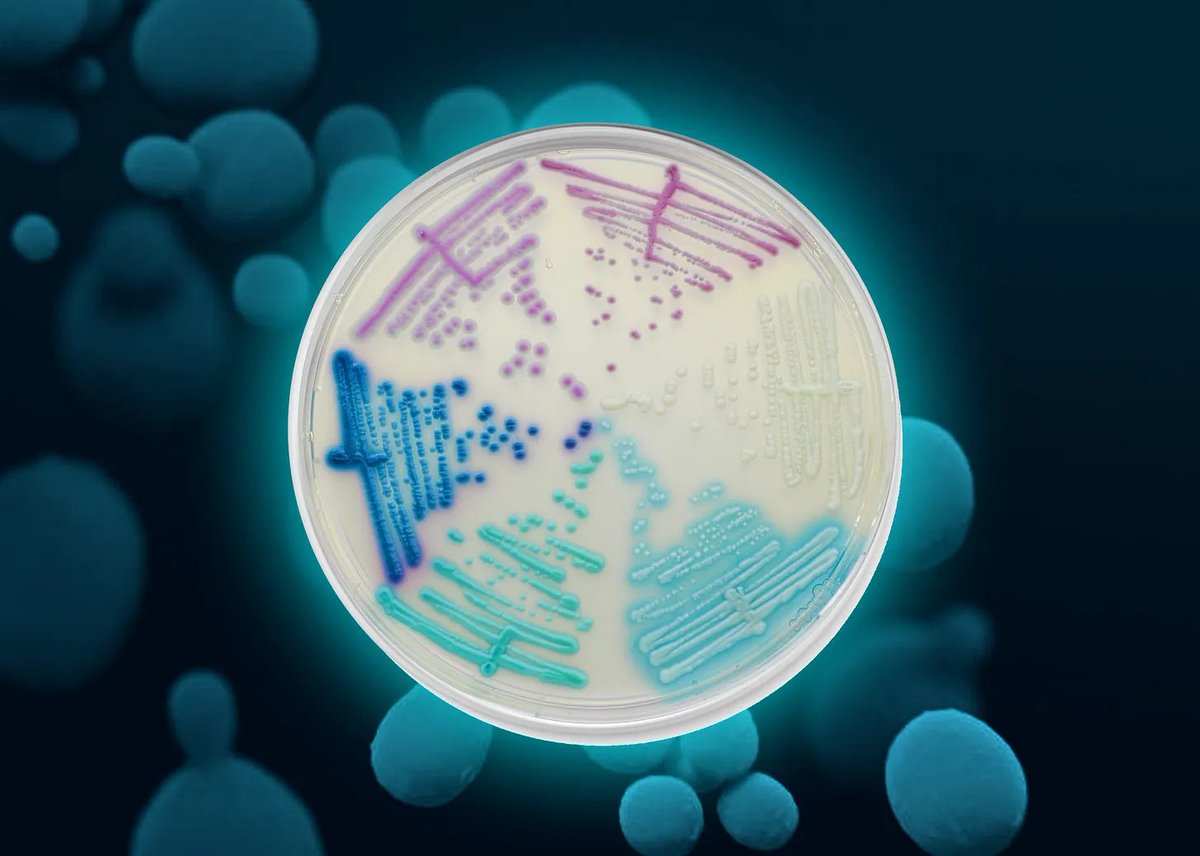

God First☦️ | All Things Health Optimization, Chronic Illness Help & Sovereign Enlightenment | DM to work 1:1
How to get URL link on X (Twitter) App


 If this resonates with you, you're probably someone who has been through the wringer trying to figure out why your brain won't cooperate with you.
If this resonates with you, you're probably someone who has been through the wringer trying to figure out why your brain won't cooperate with you.

 Facial recognition is being rolled out across U.S. airports as you read this.
Facial recognition is being rolled out across U.S. airports as you read this.

 The compound is called Cordyceps sinensis.
The compound is called Cordyceps sinensis.

 Most people think of Candida overgrowth as a simple infection. Something got out of control, so you kill it, and then you move on.
Most people think of Candida overgrowth as a simple infection. Something got out of control, so you kill it, and then you move on.

 Most people assume addiction is about pleasure. You try something, it feels good, and you keep chasing that feeling.
Most people assume addiction is about pleasure. You try something, it feels good, and you keep chasing that feeling.

 COMT (catechol-O-methyltransferase) is responsible for over 60% of dopamine clearance in the prefrontal cortex. The Val158Met polymorphism creates roughly a 25–40% variation in enzyme efficiency, producing three phenotypes:
COMT (catechol-O-methyltransferase) is responsible for over 60% of dopamine clearance in the prefrontal cortex. The Val158Met polymorphism creates roughly a 25–40% variation in enzyme efficiency, producing three phenotypes:

 A massive new study just came out called My Baby Biome. 412 infants across 48 states. And what they found is alarming.
A massive new study just came out called My Baby Biome. 412 infants across 48 states. And what they found is alarming.

 This post will cover:
This post will cover:
 The blood-brain barrier is only one cell thick. It's literally one microscopic layer of endothelial cells that stands between your brain and everything circulating in your blood.
The blood-brain barrier is only one cell thick. It's literally one microscopic layer of endothelial cells that stands between your brain and everything circulating in your blood.
Your brain fog and ADHD symptoms might not be about sleep deprivation or chronic stress. It might be candida biofilms.
Your brain fog and ADHD symptoms might not be about sleep deprivation or chronic stress. It might be candida biofilms.

 Your chronic fatigue might not be about stress or thyroid issues. It might be melanin. Yes, the pigment that determines skin color.
Your chronic fatigue might not be about stress or thyroid issues. It might be melanin. Yes, the pigment that determines skin color.

 Iron deficiency anemia and anemia of chronic disease can both make you exhausted.
Iron deficiency anemia and anemia of chronic disease can both make you exhausted.

 Think of methylation as your body's biochemical switchboard, moving tiny one-carbon units around to regulate thousands of cellular functions.
Think of methylation as your body's biochemical switchboard, moving tiny one-carbon units around to regulate thousands of cellular functions.

 From an evolutionary standpoint, our biology is inseparable from LIGHT.
From an evolutionary standpoint, our biology is inseparable from LIGHT.

 Hyperandrogenic PCOS is a common hormonal disorder that affects a TON of women.
Hyperandrogenic PCOS is a common hormonal disorder that affects a TON of women.

 Candida is a genus of yeasts that includes over 150 species of fungi.
Candida is a genus of yeasts that includes over 150 species of fungi.

 This post will go over a comprehensive list of health benefits that lactoferrin (LF) provides.
This post will go over a comprehensive list of health benefits that lactoferrin (LF) provides.

 The truth is when your liver is cooked, a couple of things will most likely happen.
The truth is when your liver is cooked, a couple of things will most likely happen. 

 #1: LACTOFERRIN
#1: LACTOFERRIN 

 Candida overgrowth is a very common problem for people with chronic gut issues.
Candida overgrowth is a very common problem for people with chronic gut issues.

 It’s pretty obvious that at this point, most pre-workouts are filled with garbage additives that are harmful for our gut and overall health…
It’s pretty obvious that at this point, most pre-workouts are filled with garbage additives that are harmful for our gut and overall health…